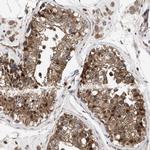
PIG3 Antibody in Immunohistochemistry (Paraffin) (IHC (P))

Search
Invitrogen
PIG3 Polyclonal Antibody
{{$productOrderCtrl.translations['antibody.pdp.commerceCard.promotion.promotions']}}
{{$productOrderCtrl.translations['antibody.pdp.commerceCard.promotion.viewpromo']}}
{{$productOrderCtrl.translations['antibody.pdp.commerceCard.promotion.promocode']}}: {{promo.promoCode}} {{promo.promoTitle}} {{promo.promoDescription}}. {{$productOrderCtrl.translations['antibody.pdp.commerceCard.promotion.learnmore']}}
产品信息
PA5-82784
种属反应
宿主/亚型
分类
类型
抗原
偶联物
形式
浓度
规格
纯化类型
保存液
内含物
保存条件
运输条件
RRID
产品详细信息
Immunogen sequence: MLAVHFDKPG GPENLYVKEV AKPSPGEGEV LLKVAASALN RADLMQRQGQ YDPPPGASNI LGLEASGHVA ELGPGCQGHW KIGDTAMALL PGGGQAQYVT VPEGLLMPIP E
Highest antigen sequence indentity to the following orthologs: Mouse - 35%, Rat - 35%.
靶标信息
The protein encoded by this gene is similar to oxidoreductases, which are enzymes involved in cellular responses to oxidative stresses and irradiation. This gene is induced by the tumor suppressor p53 and is thought to be involved in p53-mediated cell death. It contains a p53 consensus binding site in its promoter region and a downstream pentanucleotide microsatellite sequence. P53 has been shown to transcriptionally activate this gene by interacting with the downstream pentanucleotide microsatellite sequence. The microsatellite is polymorphic, with a varying number of pentanucleotide repeats directly correlated with the extent of transcriptional activation by p53. It has been suggested that the microsatellite polymorphism may be associated with differential susceptibility to cancer. At least two transcript variants encoding the same protein have been found for this gene.
仅用于科研。不用于诊断过程。未经明确授权不得转售。
篇参考文献 (0)
生物信息学
蛋白别名: NADPH:quinone reductase PIG3; p53-induced gene 3 protein; PIG3AS; Protein PIG3; quinone oxidoreductase homolog; Quinone oxidoreductase PIG3; Tumor protein p53-inducible protein 3; unnamed protein product
基因别名: PIG3; TP53I3
UniProt ID: (Human) Q53FA7
Entrez Gene ID: (Human) 9540